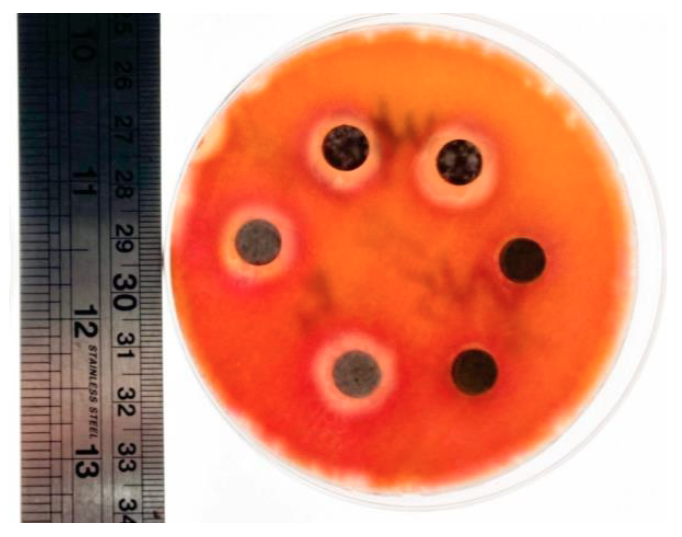
抑菌圈測試 培養皿 細菌生長抑制區域實驗結果

2026 暑假營隊
機智醫生實習營
外面好多兒童醫學營,但你還沒上過認真的!
🩺 本課程適合 10 – 18 歲(國小高年級 ~ 高中)

你有看過醫學營!但你還沒有參加過小史塔克的!
我們安排了 生理數據量測、反射與神經系統測試、自製盤尼西林、抑菌圈測試、DNA電泳、醫學影像技術,以及 解剖與縫合的外科體驗。
透過 專業外科醫師的指導,搭配 Vernier 人體系列感應器,來一場最認真的機智醫生實習營!
🔬
本營隊使用 Vernier Go Direct® 人體生理系列感應器,搭配即時數據軟體,讓孩子真正看到身體裡發生的事,而不只是聽老師說。
課程內容
實驗主題
從量數據、製藥,到親手開刀縫合——全部都玩到
📊
模組一|生理數據量測
用真實醫療等級的感應器,量測自己的心跳、呼吸、肌電、血壓,即時看到數據與圖表的變化。
心電圖/肌電圖
肺活量計
神經反射
血壓
CO₂感應
呼吸監控
🧪
模組二|自製盤尼西林
從培養青黴菌、發酵到萃取,親手重現「拯救人類的偉大發明」的研究過程,最後進行抑菌圈測試驗證結果。
青黴菌培養
萃取純化
抑菌圈測試
🔪
模組三|外科實作:解剖與縫合
在專業外科醫師指導下,進行豬腎解剖、牛眼解剖,並在縫合模擬器上練習真正的外科縫合技術。
豬腎解剖
牛眼解剖
縫合練習
醫生除了聽診器,還需要各種精密儀器做檢測。課程中我們使用 Vernier 人體系列感應器,進行各種生理數據的量測與探討,每一個數值背後都有真實的生理意義!

心電/肌電
Go Direct® EKG 感應器 — 測量心臟的放電活動與肌肉收縮時的電訊號,解析度達 24μV。用手指彎曲就能即時看到肌電圖的波形變化。

肺活量計
同時測量呼吸氣壓、流量、體積和速率 — 對比正常呼吸與深呼吸的差異,數據清晰可見。

神經反射
Go Direct® 力與加速度感應器 — 擷取槌子敲擊肌腱的力道,結合肌電圖討論神經反射。以往瞬間的反應難以量測,現在精準得到數據!

血壓
Go Direct® Blood Pressure 感應器 — 不只量血壓,還能用示波法測量收縮壓、舒張壓、平均動脈壓及脈搏率,進行更深入的討論。
CO₂感應
Go Direct® CO₂ 感應器 — 同時量測二氧化碳、溫度及相對濕度,解析度為 1ppm(百萬分之一),超精密!
呼吸監控
Go Direct® Respiration Belt 呼吸監控胸帶 — 綁於胸口,測量呼吸力道與呼吸速率的變化,並內建計步器記錄步數和步速。
大家生病時經常需要使用抗生素,最熟悉的就是盤尼西林(Penicillin)——這是一種從青黴菌中提煉出的抗生素,被譽為「拯救人類的偉大發明」!

最原始的青黴菌是在發霉的柑橘上發現的,但從一塊發霉的柑橘,到真正能治病的抗生素,還需要一個精密的萃取與純化過程。
現在,我們就帶你試著從 培養 → 發酵 → 萃取青黴素,最後進行 抑菌圈測試,完整了解這個最重要的藥物研究過程!

抑菌圈測試結果——有藥物的地方,細菌長不出來
💡
課程中孩子會親手操作培養皿,觀察抑菌圈的出現,理解為什麼「某些地方細菌長不出來」——這就是抗生素在現實中的作用方式。
螢幕裡的外科醫生手起刀落,縫合又快又好——這次,我們就在專業外科醫師的指導下,讓大家進行真正的外科手術體驗!

🫘
豬腎解剖
找到輸尿管、腎動脈、腎靜脈,並進行腎小球與鮑氏囊的顯微觀察
👁️
牛眼解剖
觀察眼睛精妙構造——網膜、玻璃體、動眼肌肉等重要結構全都看到
🪡
縫合練習
在專業縫合模擬器上練習真正的外科縫合技術,這跟縫衣服可不一樣!

🫘 豬腎解剖——找輸尿管、腎動脈、腎靜脈,觀察腎小球與鮑氏囊

👁️ 牛眼解剖——網膜、玻璃體、動眼肌肉一次看清楚

🪡 縫合練習——在香蕉和豬皮上練習真正的外科縫合技術
🏥
本堂的解剖及縫合流程皆經由專業外科醫師親自指導,確保每個步驟安全正確,也能讓孩子有最接近真實的醫學體驗。
報名資訊
班別與費用
2026 暑假開課,小班制,額滿關閉
📅
7/13(一)~ 7/17(五),連續 5 天
⏰
每日 09:00 – 17:00(含午休 1 小時)
👦
10 – 18 歲(國小五年級 ~ 高中三年級)
📍
小史塔克實驗室
💡
費用已包含全部實驗材料(培養皿、縫合模擬器耗材、Vernier 感應器使用)及午餐,報名後不需另外準備任何東西。
常見問題
家長最常問的問題
有其他問題歡迎加 LINE 直接問我們
孩子沒有醫學背景,可以參加嗎?
完全可以!課程設計從零開始,每個實驗步驟都有老師手把手帶領,不需要任何醫學或生物學基礎。只要對身體運作好奇,就是最好的出發點。
解剖實驗會讓孩子感到不舒服嗎?
課前我們會做充分的心理準備說明,並由專業醫師引導。豬腎與牛眼解剖是醫學教育中標準的入門材料,多數孩子在開始後會轉換成強烈的好奇心。若孩子確實不適應,可在一旁觀察學習,不強迫實作。
生理感應器實驗安全嗎?
Vernier Go Direct® 系列是美國教育用標準設備,全程非侵入式測量,只是貼片或綁帶的方式使用,完全安全。心電圖感應器的使用方式與一般醫院心電圖相同。
這堂課和市面上的兒童醫學營有什麼不同?
我們使用的是真實的醫療級 Vernier 感應器(非玩具),外科實作由執業外科醫師親自指導,盤尼西林製作涵蓋完整的萃取純化流程。課程強調真實數據、真實操作,而非示範演示。
可以用 1shop 點數報名嗎?
可以!1shop 會員點數可直接用於本課程報名扣款。若您有儲值方案的點數,歡迎直接使用,點數結帳免等匯款確認、卡位更快!
🩺 名額有限,認真的醫學體驗
就從這個暑假開始
7/13 – 7/17,台南安平,小班制額滿即止
有任何問題加 LINE 跟我們說一聲就好
加入 LINE 詢問報名
@starklab